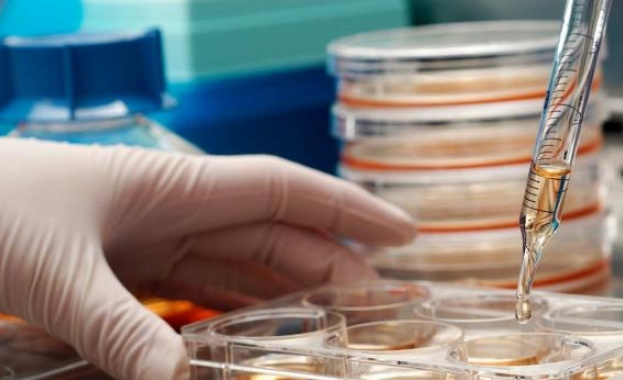
Родителите на 10 922 бебета са запазили стволовите им клетки през 2022 г.

-
 28 Апр 2026 |
28 Апр 2026 |
 USD / BGN 1.6636
USD / BGN 1.6636 GBP / BGN 2.2450
GBP / BGN 2.2450 CHF / BGN 2.1046
CHF / BGN 2.1046- Радиация: София 0.11 (µSv/h)
- Времето:
 София 0°C
София 0°C 
Родителите на 10 922 бебета са запазили стволовите им клетки през 2022 г.
24 Юли 2023 | 11:19
/КРОСС/ Предимството на съхраняваните в български тъканни банки проби е, че клетките се обработват възможно най-скоро след раждането - ключово условие за високо качество
Родителите на 10 922 новородени са пожелали извличане и съхранение на стволови клетки от пъпната връв при раждане през 2022 г. по данни на Изпълнителна агенция „Медицински надзор". През юли се провежда международната инициатива Месец за повишаване на информираността за стволовите клетки.
Целта е да се повиши образоваността на медицинските специалисти и обществото за съвременните практики при вземането, съхранението и приложението на стволови клетки от пъпна връв.
Интересът на бъдещите родители за съхранение на стволови клетки от пъпната връв при раждане нараства постепенно, като делът на запазените проби у нас се увеличава от 16 на 19% за 1 година. По данни на Националния статистически институт в България през 2021 г. са родени 58 678 деца, а според статистиката на Изпълнителна агенция „Медицински надзор" за 9133 от тях са запазени стволови клетки. През 2022 г. при общо 56 917 новородени са запазени стволови клетки за 10 922 бебета, или за 19% от всички. У нас работят активно 6 тъканни банки. От тях 3 са представителства на международни тъканни банки с разрешение да извършват само част от процеса, а именно вземането на клетки и изпращането им в лаборатория за обработка, и 3 български, които имат разрешително за целия процес - вземане, транспортиране, обработка и съхранение.
Важно е родителите да знаят, че взетите, обработени и съхранявани в България стволови клетки от пъпна връв могат да се транспортират и прилагат за лечение навсякъде по света. Стволовите клетки се извличат от кръвта и тъканта на пъпната връв, отделена и съхранена по специален начин по време на раждането. Решението за това се взема по време на бременността, като най-късно преди раждането бъдещите родители трябва да са избрали тъканна банка и да имат договор с нея.
Предимството на съхраняваните в български тъканни банки проби е, че клетките се извличат и обработват възможно най-скоро след раждането, а това е условие за замразяване и съхранение на максимално количество живи клетки. Периодът между вземането и обработката трябва да бъде възможно най-кратък. Това е ключово в целия процес, тъй като с напредването на времето необработените клетки умират.
При необходимост замразените клетки могат да се транспортират до лечебни заведения у нас и в чужбина в специални съдове при температура около минус 190 градуса, каквито са и условията на съхранение. За приложение в страни от ЕС се изисква тъканната банка, съхранила клетките, да предостави цялата необходима медицинска документация, както и декларации от родителите за тяхното желание за освобождаване на пробата стволови клетки. За страни извън ЕС допълнително е необходимо и разрешение за изнасяне на биологичен материал, което се издава от Изпълнителна агенция „Медицински надзор".
Тази година са освободени за трансплантация поредните 2 проби, частно съхранени стволови клетки в българска тъканна банка. Пробите са транспортирани до страна извън ЕС, за да бъдат приложени за повлияване на състояние от аутистичния спектър при дете.
Към днешна дата чрез стволови клетки се лекуват повече от 100 заболявания, сред които някои видове анемия, левкемии и имунни нарушения, дори СПИН. Разработват се и иновативни терапии, базирани на стволови клетки, за подобряване на състоянието при аутизъм, за лечение на диабет тип 1 и др. Със стволови клетки могат да се възстановят тъкани и дори да се създадат цели органи. Звезди на спорта като Рафаел Надал, Кристиано Роналдо и Дейвид Бекъм са предприемали терапии със стволови клетки, за да лекуват травми.